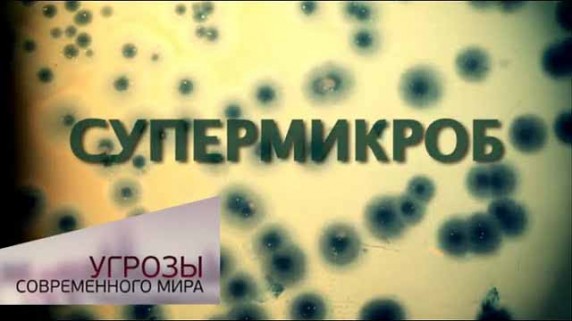

Угрозы современного мира

Угрозы современного мира
О фильме: Реалистичные версии гибели Земли и человечества! Насколько реальны шокирующие прогнозы ученых? Что уничтожит планету быстрее: агрессия Солнца, разбушевавшаяся стихия или свалка планетарного масштаба? Что убьет человека раньше: вездесущая химия, неограниченный доступ к информации или болезненная зависимость от вредных привычек? Какие побочные эффекты цивилизации наиболее опасны: массовое исчезновение видов, разрастание мегаполисов или тотальная деградация общества? Наши корреспонденты побывали в разных уголках планеты, чтобы выяснить ответы на самые животрепещущие вопросы! Пугающие выводы ведущих ученых, зрелищные эксперименты, эксклюзивные съемки, оригинальная компьютерная графика…
-
 00:26:10HD
00:26:10HD
Диагноз. Угрозы современного мира
0
-
 00:26:13HD
00:26:13HD
День зависимости. Угрозы современного мира
0
-
 00:25:42HD
00:25:42HD
Гнев Земли. Угрозы современного мира
0
-
 00:26:40HD
00:26:40HD
Химическая атака. Угрозы современного мира
0
-
 00:26:07HD
00:26:07HD
Жизнь в мегаполисе. Угрозы современного мира
0
-
 00:26:24HD
00:26:24HD
Свалка планетарного масштаба. Угрозы современного мира
0
-
 00:26:25HD
00:26:25HD
Невидимая опасность. Угрозы современного мира
0
-
 00:24:52HD
00:24:52HD
Демография. Болезнь роста. Угрозы современного мира
0
-
00:25:18HD
00:25:18HD
Супермикроб. Угрозы современного мира
0
-
 00:25:03HD
00:25:03HD
Демография. Болезнь роста. Угрозы современного мира - Наука
0
-
 00:26:11HD
00:26:11HD
Атомная альтернатива. Угрозы современного мира (2017)
0
-
 00:26:39HD
00:26:39HD
Атомный краш-тест. Угрозы современного мира
0
Нет комментариев. Ваш будет первым!